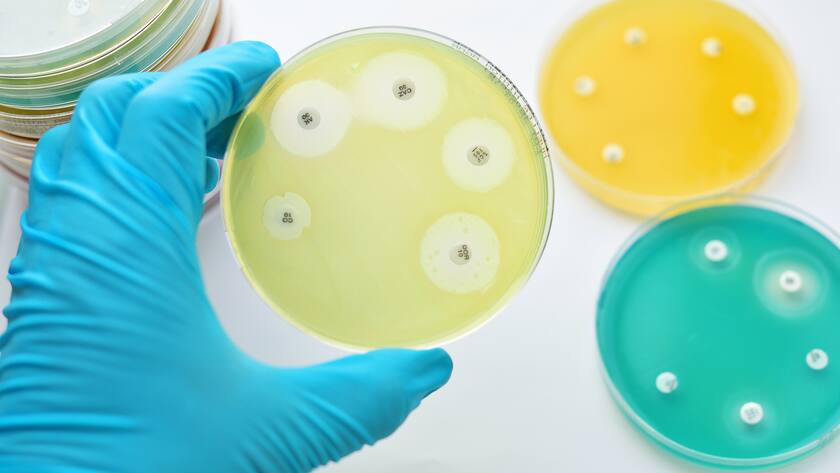
Polyphor

Verheissung sieht anders aus. Der Hegenheimermattweg in Allschwil, Sitz des 65 Mitarbeiter zählenden Biotechunternehmens Polyphor, liegt am Stadtrand von Basel – zwischen Lagerhallen, Tennisplätzen und Schrebergärten.
Doch dem Allschwiler Biotechwinzling könnte gelingen, was die Industrie vor einem halben Jahrhundert das letzte Mal hingekriegt hat: ein Schmalspektrum-Antibiotikum gegen ein gramnegatives Bakterium auf den Markt zu bringen. Ziel sind resistente Stämme des vor allem in amerikanischen und südeuropäischen Krankenhäusern besonders gefürchteten Bakteriums Pseudomonas aeruginosa.
Nun will das Unternehmen an die Börse. Das Ziel: 100 bis 150 Millionen Franken, um das Antibiotikum Murepavadin durch die letzte Phase der Entwicklung zu bringen.
Eine Wette auf die Zukunft
Der Börsengang von Polyphor ist wie der jedes Biotechunternehmens ohne marktreifes Produkt: eine Wette mit viel Einsatz und Unsicherheit. Vielversprechende Produktkandidaten sind noch lange kein Garant für kommerziellen Erfolg.
Generell wird geschätzt, dass bis zu 40 Prozent aller Wirkstoffkandidaten auf der letzten Meile, der dritten Phase der klinischen Entwicklung, der Schnauf ausgeht – mit erheblichen Kostenfolgen für die Unternehmen. Studien der klinischen Phase III kosten in der Regel mehrere 100 Millionen Franken.
Wirkstoff greift Proteine an
Doch es gibt eine Reihe von Argumenten, die dafür sprechen, dass Polyphor das Rennen machen könnte. Murepavadin – so der Name des Hoffnungsträgers – verfügt über einen ausgeklügelten Wirkungsmechanismus.
Der Wirkstoff greift ein Protein an, das für die Bildung der bei gramnegativen Bakterien besonders dicken, lebensnotwendigen «Aussenwand» verantwortlich ist. Wird es blockiert, so geht das Bakterium zugrunde.
Das Unternehmen sprach dieser Tage von einer «extrem potenten Aktivität» des Wirkstoffs. Frühere Studien hatten Heilungsraten von 80 bis 90 Prozent gezeigt und auch die Mortalitätsrate konnte stark reduziert werden.
Tiefe Hürden für eine Anwendung
Doch der Wirkstoff hat noch einen anderen Vorteil. Anders als die meisten Wirkstoffe, die sich zurzeit in der klinischen Entwicklung befinden, ist der Wirkstoff nicht von bereits kommerzialisierten Antibotika abgeleitet.
Das heisst: Das Risiko einer schnellen Resistenzbildung ist kleiner; entsprechend tiefer sind die Hürden für die Ärzte, das Produkt im Spitalalltag auch einzusetzen.
Dazu kommt: In den nächsten Jahren dürften Schnelltests auf den Markt kommen, welche die Zeit bis zur Diagnose einer Infektion von heute zwei bis drei Tagen stark verkürzen werden. Auch das spielt Polyphor in die Hände.

Giacomo Di Nepi: Der CEO will das Unternehmen an die Börse führen.
Bis zu 40 Prozent sterben
Klar ist, dass es sich beim Bakterium Pseudomonas aeruginosa um eine der besonders gefürchteten Krankenhausinfektionen handelt. Die Infektion führt zu Lungenentzündungen und betrifft vor allem bereits geschwächte Patienten auf der Intensivstation, die beatmet werden. Schätzungen zufolge kommt es in den USA und Europa jährlich zu rund 300 000 Infektionen. Die Sterblichkeit ist gross. Eine Infektion mit einem resistenten Bakterium führt bei 30 bis 40 Prozent der Fälle zum Tod.
Wirksam, neu, gezielt, grosser medizinischer Nutzen: Der Wirkstoff passt bestens ins «Beuteschema» der Politiker, die sich die Bekämpfung der Antibiotikaresistenzen im Rahmen der Weltgesundheitsorganisation WHO und G20 auf die Fahne geschrieben haben. Bestenfalls führt dies dazu, dass das noch immer zu tiefe Preisniveau für neue Antibiotika angehoben wird – ein Szenario, das Polyphor zusätzlich zugute käme.
Ab Mitte Mai werden die Aktien an der Börse gehandelt.
Erfolg in den USA
Die Polyphor-Mannschaft um Giacomo Di Nepi, ehemals Roche und Intermune, hat derweil dieser Tage auf einem anderen Feld gepunktet. Die amerikanische Zulassungsbehörde FDA hat Balixafortide, einem Immunonkologietherapeutikum von Polyphor, ein beschleunigtes Zulassungverfahren zugestanden.
Giacomo Di Nepis früherer Arbeitgeber Intermune wurde 2014 von Roche für rund 8 Milliarden Franken übernommen, nachdem es mehr oder weniger aus dem Nichts ein Medikament gegen idiopathische Lungenfibrose entwickelt hatte. Doch die Rechnung ging auf. Die Übernahme entpuppte sich als wahre Goldgrube für Roche.
Jetzt muss Giacomo Di Nepi nur noch schauen, dass sich die Geschichte wiederholt.